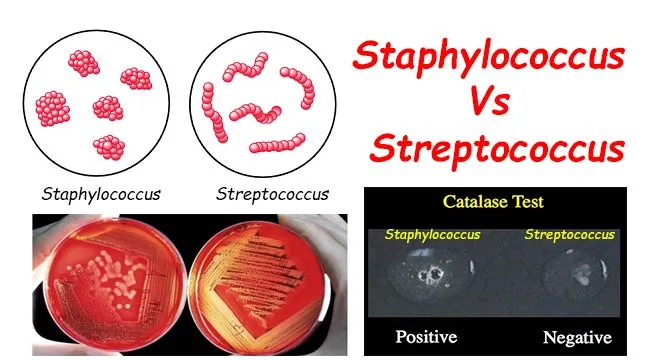
Staphylococcus vs Streptococcus: Morphology & Catalase

Microscopy & Staining - Peep & Paint Bugs
- Microscopy: Light (Bright-field, Dark-field, Phase-contrast, Fluorescence), Electron (TEM, SEM).
- Staining Types:
- Simple (e.g., Methylene blue)
- Differential: Gram, Acid-fast (Ziehl-Neelsen)
- Special: Capsule (India ink), Spore (Malachite green), Flagellar (Leifson’s)
- Gram Staining: 📌 Mnemonic: Come In And Stain (Crystal Violet, Iodine, Alcohol, Safranin).
- Principle: Differentiates based on cell wall peptidoglycan thickness.

- Ziehl-Neelsen (ZN) Stain: For Acid-Fast Bacilli (AFB).
- Principle: Mycolic acid in cell wall resists decolorization by acid-alcohol.
- Examples: Mycobacterium tuberculosis, Nocardia spp.

- Albert's Stain: For Corynebacterium diphtheriae (detects metachromatic granules).
⭐ The mordant used in Gram staining is Gram's Iodine, which forms an insoluble Crystal Violet-Iodine (CV-I) complex, crucial for the retention of crystal violet by Gram-positive bacteria.
Culture Methods - Grow & Glow Show
| Type | Examples (Key Use) |
|---|---|
| Basal | Nutrient Agar (Basic growth) |
| Enriched | Blood Agar (Haemolysis), Choc. Agar (H.flu, Neisseria: X,V factors) |
| Selective | MacConkey, LJ (M.tb), TCBS (Vibrio: yellow colonies) |
| Differential | MacConkey (LF pink/NLF colorless), Blood Agar, CLED |
| Transport | Stuart's, Amies (Preserve sample) |
| Anaerobic | RCM, Thioglycollate Broth (Anaerobes) |
- Colony: Size, Shape, Edge, Surface, Colour, Odour (Pseudomonas: fruity).
- Atmosphere: Aerobes, Anaerobes, Facultative, Microaerophilic, Capnophilic. Temp: 37°C.

⭐ Chocolate agar: heated blood lyses RBCs, releasing X (hemin) & V (NAD) factors for fastidious organisms like Haemophilus influenzae.
Biochemical Tests - Bug's Chemical Fingerprints
- Catalase: $2H_2O_2 \rightarrow 2H_2O + O_2$. Staph (+ve) vs Strep (-ve).
- Oxidase: Detects cytochrome c oxidase. Neisseria, Pseudomonas (+ve) vs Enterobacteriaceae (-ve, except Plesiomonas).

- Coagulase: Fibrinogen $\rightarrow$ fibrin. S. aureus (+ve) vs CoNS (-ve).
- Urease: Urea $\rightarrow$ ammonia + $CO_2$. Proteus, Klebsiella, H. pylori (+ve).
- Indole: Tryptophan $\rightarrow$ indole. E. coli (+ve).
- Citrate: Utilizes citrate as sole carbon source. Klebsiella, Enterobacter (+ve).
- Triple Sugar Iron (TSI) Agar: Fermentation (glucose, lactose, sucrose); $H_2S$; gas.
⭐ TSI: glucose (0.1%), lactose (1%), sucrose (1%); phenol red (pH); ferrous sulfate ($H_2S$ detection).
- IMViC: (Indole, Methyl Red, Voges-Proskauer, Citrate).
- 📌 Mnemonic: Ek Cutta India Mein Vomiting Carta hai - E.coli (++--), Klebsiella (--++).
Serological & Molecular - Antibody & Gene Sleuths
Serological Methods: (Antigen-Antibody reactions)
- Agglutination: Particulate Ag + Ab → Clumping.
- Widal test: Typhoid fever.
- Slide agglutination: Rapid bacterial typing.
- Precipitation: Soluble Ag + Ab → Insoluble precipitate.
- VDRL (flocculation): Syphilis screening.
- ELISA (Enzyme-Linked Immunosorbent Assay): Enzyme-labelled Ab/Ag detection.
- Types: Direct, Indirect, Sandwich, Competitive.
- Uses: HIV screening, detecting microbial Ag/Ab.
- Immunofluorescence (IF): Fluorescent dye-labelled Ab.
- Types: Direct (DFA) detects Ag, Indirect (IFA) detects Ab.
- Western Blot: Confirmatory (e.g., HIV, Lyme); identifies specific proteins post-electrophoresis.
Molecular Methods: (Nucleic acid detection)
- PCR (Polymerase Chain Reaction): Amplifies specific DNA/RNA sequences.
- Types: RT-PCR (RNA targets), qPCR (quantitative), Multiplex PCR.
- Uses: MTB, viral detection (HIV, HCV), antimicrobial resistance genes.
- Nucleic Acid Probes & Hybridization: Labelled probes detect specific gene sequences.
- 16S rRNA Gene Sequencing: Identifies difficult-to-culture bacteria, phylogenetic studies.
- MALDI-TOF MS (Matrix-Assisted Laser Desorption/Ionization Time-Of-Flight Mass Spectrometry): Rapid identification via ribosomal protein profiling.
⭐ MALDI-TOF MS can identify bacteria within minutes from a single colony, revolutionizing clinical microbiology laboratory workflows.
High‑Yield Points - ⚡ Biggest Takeaways
- Gram staining (peptidoglycan) & Ziehl-Neelsen (acid-fast) are primary staining methods.
- Culture on selective/differential media is vital for isolation & preliminary ID.
- Key biochemical tests include catalase, oxidase, coagulase, & IMViC series.
- Serological methods like agglutination & ELISA detect specific Ag-Ab reactions.
- PCR & nucleic acid probes offer rapid, highly specific molecular identification.
- MALDI-TOF MS provides rapid bacterial identification via proteomic fingerprinting.
Unlock the full lesson and continue reading
Signup to continue reading this lesson and unlimited access questions, flashcards, AI notes, and more